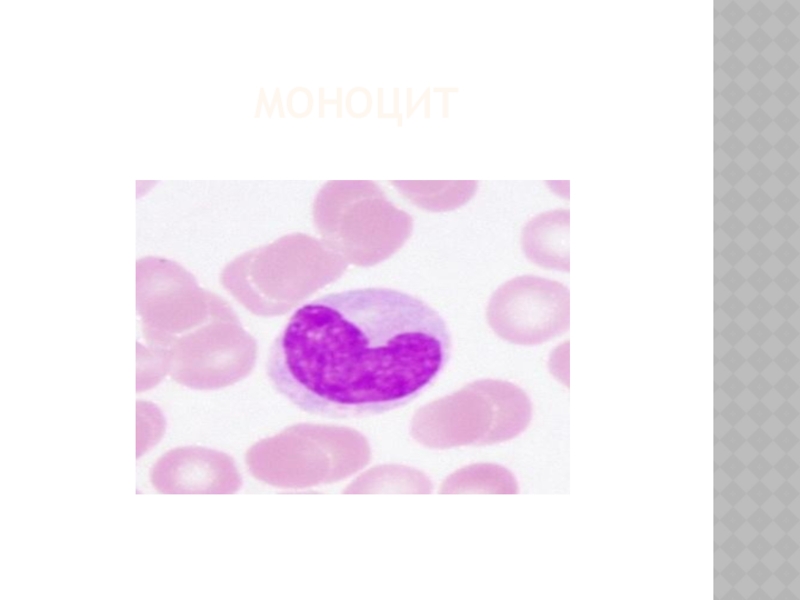
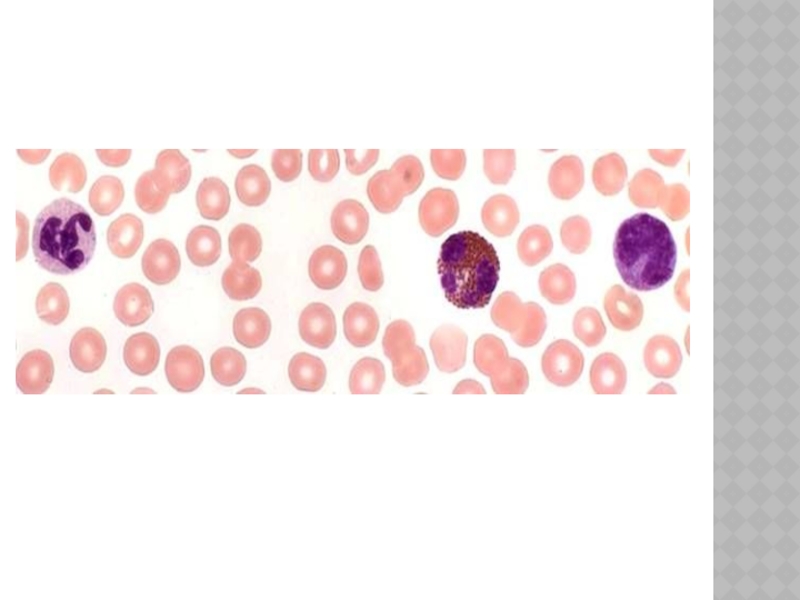

ткани. Клетки (форменные элементы), плазма.
58.Эритроциты. Особенности строения и функция. Видовые
особенности. Эритропоэз (развитие).59.Лейкоциты, их классификация, строение, функция. Лейкоцитарная формула.
60.Лейкоциты-агранулоциты: классификация, строение, функция. Участие в иммунных реакциях.
61.Лейкоциты-гранулоциты: классификация, функция. Гранулоцитопоэз. (развитие)
62.Моноциты-макрофаги. Понятие о системе мононуклеарных фагоцитов. Моноцитопоэз.
63.Кровяные пластинки (тромбоциты). Тромбоцитопоэз.
64.Иммунные клетки, их кооперация (Т-, В-лимфоциты, макрофаги).